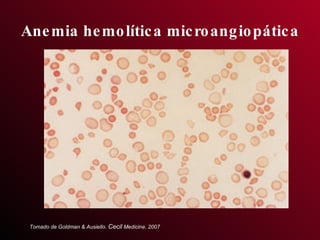
Anemia hemolítica microangiopática Tomado de Goldman & Ausiello.  Cecil  Medicine. 2007
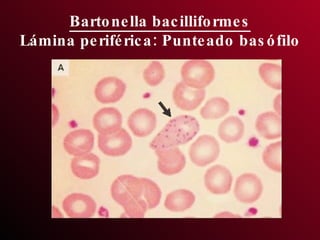
Bartonella bacilliformes Lámina periférica: Punteado basófilo

El documento resume las principales características de las anemias hemolíticas. Define las anemias hemolíticas como congénitas o adquiridas, corpusculares o extracorpusculares, e intravasculares o extravasculares. Describe las manifestaciones clínicas como palidez, ictericia, dolor óseo y abdominal, y órganos agrandados. Explica las pruebas de laboratorio que indican hemólisis como reticulocitos y bilirrubina elevados. Finalmente, clasifica y describe en detalle los principales tipos de anem